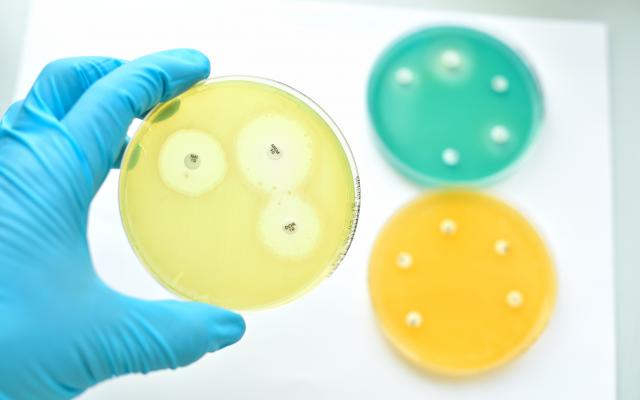
Drie petrischaaltjes.

Anne van Kessel spreekt in #4 van de NTvG-podcast met Esther Oldekamp over het beroepsgeheim van de arts wanneer patiënten zelf iemand meebrengen, en met medisch microbioloog Bas Franssens over de wijziging van het antibiogram. De warme douche is voor longarts en activist Wanda de Kanter en Jop de Vrieze interviewt de initiatiefnemer van het ‘ballenalarm’, Berend van Doorn.
Wil je op de hoogte blijven? Schrijf je dan in voor het dossier Podcast en ontvang direct een e-mail wanneer een nieuwe aflevering online staat.
Externe links